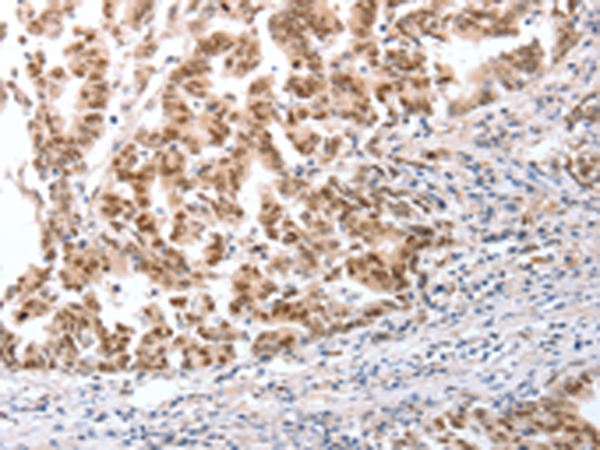

中文名稱:兔抗CTBP2多克隆抗體
|
Background: |
This gene produces alternative transcripts encoding two distinct proteins. One protein is a transcriptional repressor, while the other isoform is a major component of specialized synapses known as synaptic ribbons. Both proteins contain a NAD+ binding domain similar to NAD+-dependent 2-hydroxyacid dehydrogenases. A portion of the 3' untranslated region was used to map this gene to chromosome 21q21.3; however, it was noted that similar loci elsewhere in the genome are likely. Blast analysis shows that this gene is present on chromosome 10. |
|
Applications: |
ELISA, IHC |
|
Name of antibody: |
CTBP2 |
|
Immunogen: |
Fusion protein of human CTBP2 |
|
Full name: |
C-terminal binding protein 2 |
|
SwissProt: |
P56545 |
|
IHC positive control: |
Human gastric cancer and human ovarian cancer |
|
IHC Recommend dilution: |
25-100 |
購物車
購物車 幫助
幫助
 021-54845833/15800441009
021-54845833/15800441009
